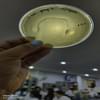

Admission to the college requires clearing the KIITEE entrance exam, followed by counseling and shortlisting through interviews. Candidates must pay both counseling and admission fees. The college offers a unique dual technology degree in biotechnology. The faculty, while strict, are effective and supportive in research and internships, with a balanced faculty-to-student ratio. The per-semester fee is Rs. 1,89,500, including institutional, mess, and hostel costs, which is comparatively high. Hostel fees are Rs. 21,000 for a 3-bed non-AC room, and mess fees are Rs. 17,000 per semester.
Tuition fees rise biennially and are currently Rs. 1,50,000. Scholarships and education loans are available for financial assistance. Campus placements have a high success rate, with a 95% placement rate for the 2016 batch and 3,800 job offers. Initial stipends during training are Rs. 12,000, with salary packages ranging from 4 to 12 lakhs, depending on the position. Prominent recruiters include GSK, Biocon, and Unilever. Students have opportunities for major internships in their final year, typically concluding with a thesis.
Scholarships are awarded based on entrance exam performance, maintaining a high CGPA, and being a semester topper. The university provides scholarship opportunities to foreign students and offers a free school for underprivileged students. The fee structure increases annually, with last year's fees at Rs. 1,75,000 and this year's at Rs. 1,95,000.

![Kalinga Institute of Industrial Technology - [KIIT]](https://image-static.collegedunia.com/public/college_data/images/logos/1394450211Kalinga Institute of Industrial Technology.png?h=71.7&w=71.7&mode=stretch)

.png?h=78&w=78&mode=stretch)
.png?h=78&w=78&mode=stretch)

![IIT Bhubaneswar - Indian Institute of Technology - [IITBBS]](https://image-static.collegedunia.com/public/college_data/images/appImage/148491861525759app.png?h=111.44&w=263&mode=stretch)

![International Institute of Information Technology - [IIIT]](https://image-static.collegedunia.com/public/college_data/images/appImage/1508756242cvr.png?h=111.44&w=263&mode=stretch)

![Centurion University of Technology and Management - [CUTM]](https://image-static.collegedunia.com/public/college_data/images/appImage/1498559311Appnew.jpg?h=111.44&w=263&mode=stretch)



![Odisha University of Technology and Research-[OUTR]](https://image-static.collegedunia.com/public/college_data/images/appImage/28535_cet_new.jpg?h=111.44&w=263&mode=stretch)

![CIPET: Centre for Skilling and Technical Support [CSTS]](https://image-static.collegedunia.com/public/college_data/images/appImage/13179_CIPET_New.jpg?h=111.44&w=263&mode=stretch)













![KIIT School of Fashion Technology - [KSOFT]](https://image-static.collegedunia.com/public/college_data/images/logos/1679312764Screenshot20230320171527.png?h=72&w=72&mode=stretch)
![Kalinga Institute of Dental Sciences - [KIDS]](https://image-static.collegedunia.com/public/college_data/images/logos/1605950252download.png?h=72&w=72&mode=stretch)
![KIIT School of Law - [KSOL]](https://image-static.collegedunia.com/public/college_data/images/logos/15124691631394450211KalingaInstituteofIndustrialTechnology.png?h=72&w=72&mode=stretch)
![Kalinga Institute of Medical Sciences - [KIMS]](https://image-static.collegedunia.com/public/college_data/images/logos/1601804451Logo.png?h=72&w=72&mode=stretch)

![KIIT School of Management - [KSOM]](https://image-static.collegedunia.com/public/college_data/images/logos/1693997827channels4profile.jpg?h=72&w=72&mode=stretch)
![KIIT School of Rural Management - [KSRM]](https://image-static.collegedunia.com/public/college_data/images/logos/1760093336download14.png?h=72&w=72&mode=stretch)
![KIIT School of Computer Application - [KSCA]](https://image-static.collegedunia.com/public/college_data/images/logos/1608039459Logo.png?h=72&w=72&mode=stretch)
![KIIT School of Computer Engineering - [KSCE]](https://image-static.collegedunia.com/public/college_data/images/logos/1429525504kiit computer engeeniaring.jpg?h=72&w=72&mode=stretch)

.png?h=72&w=72&mode=stretch)
.png?h=72&w=72&mode=stretch)


.png?h=72&w=72&mode=stretch)


![KIIT School of Biotechnology - [KSBT]](https://image-static.collegedunia.com/public/college_data/images/logos/1473762193Logo.png?h=72&w=72&mode=stretch)
![Kalinga Institute of Nursing Sciences - [KINS]](https://image-static.collegedunia.com/public/college_data/images/logos/1603191564Logo.jpg?h=72&w=72&mode=stretch)

![KIIT School of Design - [KSOD]](https://image-static.collegedunia.com/public/college_data/images/logos/1710591009kiitdesignlogo600x1341.png?h=72&w=72&mode=stretch)



![KIIT School of Leadership- [KSLD]](https://image-static.collegedunia.com/public/college_data/images/logos/1763706807ksldla.jpeg?h=72&w=72&mode=stretch)
![Birla Global University - [BGU]](https://image-static.collegedunia.com/public/college_data/images/logos/1654260652bgulogo.png?h=72&w=72&mode=stretch)


![Centurion University of Technology and Management - [CUTM]](https://image-static.collegedunia.com/public/college_data/images/logos/16189222067038315326908908642635764348829995527831552n.jpg?h=72&w=72&mode=stretch)
![Sri Sri University - [SSU]](https://image-static.collegedunia.com/public/college_data/images/logos/1506508878logo.jpg?h=72&w=72&mode=stretch)
![GITA Autonomous College - [GITA College]](https://image-static.collegedunia.com/public/college_data/images/logos/1623431523gitalog.png?h=72&w=72&mode=stretch)
![Institute of Engineering and Management - [IEM]](https://image-static.collegedunia.com/public/college_data/images/logos/1618146864Capture.jpg?h=72&w=72&mode=stretch)
![Birla Institute of Technology - [BIT Mesra]](https://image-static.collegedunia.com/public/college_data/images/logos/1406023982download.jpg?h=72&w=72&mode=stretch)

![GIET University - [GIET]](https://image-static.collegedunia.com/public/college_data/images/logos/1620738578UniversityLogo1.png?h=72&w=72&mode=stretch)
![Siksha 'O' Anusandhan University - [SOA]](https://image-static.collegedunia.com/public/college_data/images/logos/1619098174SOAPNG.png?h=72&w=72&mode=stretch)


![Indian Institute of Information Technology Design and Manufacturing - [IIITDM]](https://image-static.collegedunia.com/public/college_data/images/logos/1565250447220pxIndianInstituteofInformationTechnologyDesignandManufacturingKurnoollogo.png?h=72&w=72&mode=stretch)
![Lovely Professional University - [LPU]](https://image-static.collegedunia.com/public/college_data/images/logos/1744630559Screenshot20250414at16.47.48.png?h=72&w=72&mode=stretch)


Comments